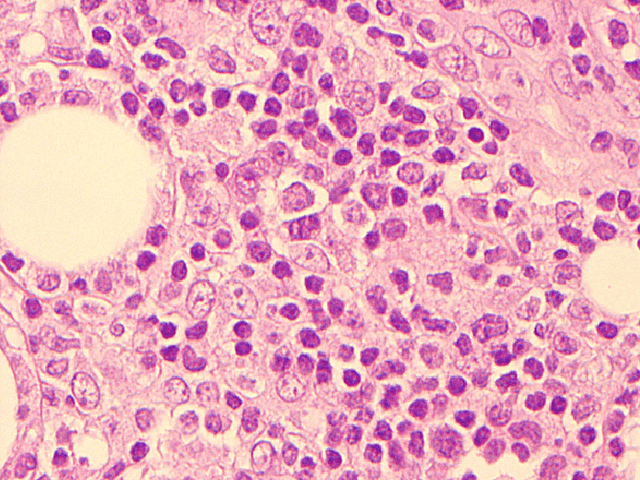
ARPANET

-
Los EEUU fundaron la Advanced Research Projects Agency Network o Red de la Agencia para los Proyectos de Investigación Avanzada de los Estados Unidos (ARPA) a través del Ministerio de Defensa.
-
Nació ARPANET, la primera conexión entre los ordenadores de Standford y UCLA.
Looking for a timeline maker?
Create timelines for projects, roadmaps, history, lessons, legal cases, and stories with Timetoast. Timetoast is a timeline maker for work, school, research, and stories.